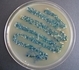
Analiza mikrobiologiczna produktów kosmetycznych i farmaceutycznych

-
Informacje
Nowości & aktualności -
Testy sprzętu
Opinie ekspertów -
Kalkulatory
Zestaw narzędzi -
Laboratoria
Adresy & oferta -
Praca
Oferty zatrudnienia -
Kalendarium
Wydarzenia branżowe -
Kontakt
 Ocena bezpieczeństwa kosmetyków - teoria i warsztaty2015-09-29 - 2015-09-29, ŁódźKosmetologia, Szkolenia BTM |


|
 |


|
 ZAPŁAĆ ZA SZKOLENIE ILE CHCESZ - SPRAWDŹ NASZĄ OFERTĘ2015-10-01 - 2015-10-31, Hotel Ibis Warszawa Centrum, Al. Solidarności 165Farmacja, Biotechnologia, Kosmetologia |


|
 Techniki in vitro badania biozgodności nanomateriałów2015-10-01 - 2015-10-03, WarszawaFarmacja, Kosmetologia, Biotechnologia |


|
 42th Congress of International Society of Oncology and BioMarkers "Oncology in the Biomarker Era: Biology - Diagnostics - Therapy"2015-10-03 - 2015-10-07, ZakopaneBiotechnologia |


|
Oncology in the Biomarker Era: Biology – Diagnostics – Therapy2015-10-03 - 2015-10-07, ZakopaneBiotechnologia |


|
 |


|
 42th Congress of International Society of Oncology and BioMarkers "Oncology in the Biomarker Era: Biology - Diagnostics - Therapy"2015-10-03 - 2015-10-07, ZakopaneBiotechnologia |


|
Konferencja - medycyna, farmacja i kosmetyka2015-10-05 - 2015-10-05, ŁódźFarmacja, Biotechnologia, Kosmetologia |


|
 INVITATION to BIOTECHNICA and LABVOLUTION Trade Press Conference in Hannover2015-10-06 - 2015-10-08, HannoverBiotechnologia |


|
 |


|
 BIOTECHNICA and LABVOLUTION Trade Press Conference2015-10-06 - 2015-10-08, Hannover, NiemcyFarmacja, Biotechnologia, Kosmetologia |


|
Optymalizacja zużycia energii i kosztów działalności przedsiębiorstwa produkcyjnego2015-10-08 - 2015-10-08, WrocławFarmacja, Biotechnologia, Kosmetologia |


|
 |


|
 Chromatografia gazowa z detektorem spektrometrii mas (MS)– specjalistyczny kurs laboratoryjny2015-10-09 - 2015-10-11, KatowiceFarmacja, Biotechnologia, Kosmetologia |


|
Analiza mikrobiologiczna produktów kosmetycznych i farmaceutycznych2015-10-09 - 2015-10-09, PPNT Gdynia, aleja Zwycięstwa 96/98Farmacja, Kosmetologia |


|
 Zasady i Procedury Dobrej Praktyki Laboratoryjnej. Wymagania dotyczące personelu w Laboratorium Akredytowanym wg normy PN-EN ISO 170252015-10-10 - 2015-10-10, WrocławFarmacja, Biotechnologia, Kosmetologia |


|
 |


|
 Chromatografia cieczowa HPLC- specjalistyczny kurs laboratoryjny.2015-10-12 - 2015-10-14, GdyniaFarmacja, Biotechnologia, Kosmetologia |


|
XIX. Konferencja Naukowa BIOCYBERNETYKA I INŻYNIERIA BIOMEDYCZNA2015-10-14 - 2015-10-16, WarszawaBiotechnologia |


|
 Seminarium "Dzień Projektożerców"2015-10-15 - 2015-10-15, GliwiceFarmacja, Biotechnologia, Kosmetologia |


|
 Wprowadzenie do obróbki danych NGS2015-10-16 - 2015-10-16, Wydział Biologii UAM w PoznaniuFarmacja, Biotechnologia, Kosmetologia |


|
 Osoba Odpowiedzialna w hurtowni farmaceutycznej2015-10-20 - 2015-10-20, Hotel Ibis Warszawa Centrum, Al. Solidarności 165Farmacja, Biotechnologia, Kosmetologia |


|
 Fifth Central European Life Science Investment Conference2015-10-22 - 2015-10-23, Kraków, Hotel StaryBiotechnologia |


|
 Fifth Central European Life Science Investment Conference2015-10-22 - 2015-10-23, Hotel Stary, KrakówFarmacja, Biotechnologia |


|
 Fifth Central European Life Science Investment Conference2015-10-22 - 2015-10-23, KrakówBiotechnologia |


|
|
|


|
 Chromatografia gazowa z detektorem spektrometrii mas (MS)– specjalistyczny kurs laboratoryjny2015-10-23 - 2015-10-25, KatowiceFarmacja, Biotechnologia, Kosmetologia |


|
 Konferencja naukowo-jubileuszowa Instytutu Nauk Fizykomedycznych2015-10-24 - 2015-10-24, PoznańFarmacja, Biotechnologia |


|
 Mikrobiologia w Medycynie, Przemyśle i Ochronie Środowiska2015-10-24 - 2015-10-25, ŁódźFarmacja, Biotechnologia |


|
 Zasady i Procedury Dobrej Praktyki Laboratoryjnej. Wymagania dotyczące personelu w Laboratorium Akredytowanym wg normy PN-EN ISO 17025.2015-10-28 - 2015-10-28, KatowiceFarmacja, Biotechnologia, Kosmetologia |


|
 Kwalifikacja i walidacja w hurtowni farmaceutycznej2015-10-28 - 2015-10-29, Hotel Ibis Warszawa Centrum, Al. Solidarności 165Farmacja, Biotechnologia, Kosmetologia |


|
 Opakowanie i oznakowanie produktów kosmetycznych - nowe trendy, wymiary prawne, aspekty marketingowe2015-10-28 - 2015-10-28, ŁódźKosmetologia, Szkolenia BTM |


|
 |


|
 Design Thinking Week 20152015-11-02 - 2015-11-09, Centrum Zarządzania Innowacjami i Transferem Technologii Politechniki WarszawskiejFarmacja, Biotechnologia |


|
Mając na względzie ochronę i bezpieczeństwo Twoich danych osobowych, firma Bio-Tech Media sp. z o.o., przykładając szczególną wagę do ich ochrony, dostosowała swoje zasady ich przetwarzania do obowiązującego od dnia 25 maja 2018 roku Rozporządzenia Parlamentu Europejskiego i Rady (UE) z dnia 27 kwietnia 2016 r. nr 2016/679
Nasza zaktualizowana polityka prywatności wprowadza wszystkie pozytywne zmiany, w tym sposób, w jaki zbieramy, przetwarzamy i przechowujemy Twoje dane osobowe. Przedstawia sposób, w jaki możesz się z nami skontaktować, aby skorzystać z przysługujących Ci praw.
W tej chwili nie musisz podejmować żadnych działań, ale jeśli chcesz dowiedzieć się więcej, zapoznaj się z naszą polityką prywatności.
Zapoznaj się z naszą polityką prywatności ›